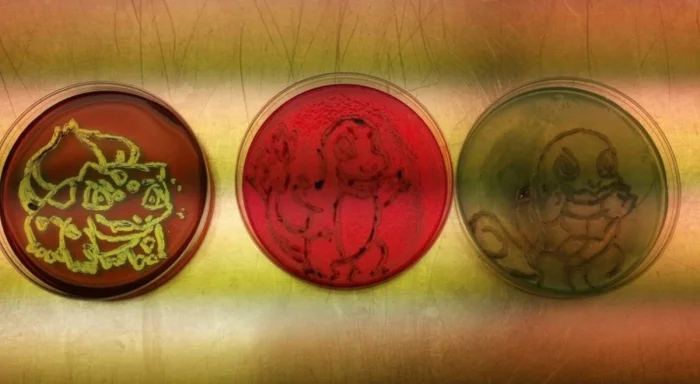

20 человек, которые работают с максимальной отдачей
Эта коллекция рассказывает о тех, кто вкладывает в свою работу всю душу, стремясь к совершенству. Они трудятся не через силу, а с искренней отдачей, внося в каждое дело частичку себя.

1. Уборщица вышла за рамки своих обязанностей, и это впечатляет!

2. Учитель из Ирана навестил больного ученика, чтобы объяснить урок

3. Парамедики не только доставили мать троих детей в больницу, но и помыли её посуду

4. Сотрудник магазина превратил расстановку товаров в настоящее искусство

5. Магазин принял возврат товара спустя 17 лет после покупки

6. Французский луковый суп подается в настоящей луковице — уникальная идея ресторана

7. Учитель математики создал для детей настоящую рождественскую магию

8. Завтрак в отеле во время пандемии: продукты, тостер и молоко в упаковке

9. Перфекционисты демонстрируют свои навыки с аплодисментами!

10. Сотрудница фастфуда проявила креативность в выборе головного убора

11. Вечернее время — идеальный момент для творчества

12. Фотоотчет о присмотре за собакой — работа выполнена на отлично

13. Лаборант создал художественные изображения бактерий в чашках Петри
14. Официантки заботятся о клиенте, чтобы он не проливал напитки

15. Туннели под железнодорожными путями спасают жизнь черепахам

16. Учительница спасла котенка по дороге на работу

17. Артефакт в музее, память о всех погибших пожарных

18. Не только красиво, но и удобно для администрирования

19. Раз в год библиотекарь наряжается как смерть, чтобы собрать не сданные книги

20. Когда постоялец попросил номер в отеле с бонусом, в виде принта на подушку с ликом Николаса Кейджа, он даже не ожидал, что они так сделают



Он трудился на самой низкооплачиваемой работе, но все равно сумел заработать на первый взнос в колледж
